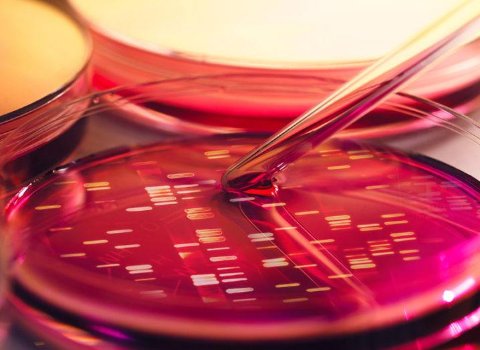

The ability to store digital information in DNA has been one of the most fascinating pursuits of genetic researchers in recent years, with the human body seen as the ultimate storage device for the zettabytes of information expected to be generated in the coming decades by a myriad of different devices.
There is also the issue of preserving the legacy of our species, as hard drives of the future will simply be unable to stand the test of time – but DNA could be preserved for potentially millions of years.
Already, genetic researchers and computer scientists have created early prototypes, demonstrating the ability to code an entire movie and an operating system directly into DNA.
Even in Ireland, start-ups such as Helixworks are already offering the service of coding text in DNA on Amazon.
On that note, the Telecommunications Software and Systems Group (TSSG) based at the Waterford Institute of Technology (WIT) has unveiled a new and improved storage solution that enables researchers to store information in different types of bacteria for the first time.
Until now, it had only been possible to simply encode data on DNA and then decode it again, but this method can store data significantly longer.
E coli and Novablue
According to RTÉ, the team of researchers encoded the message ‘Hello World’ into circular rings of double-stranded DNA known as plasmids.
Then, it was a matter of storing the plasmids on a strain of the E coli bacteria known as Novablue, which is then trapped in a very specific location, transforming it into a data storage device.
Another form of E coli bacteria called HB101 becomes the ‘USB stick’ whereby the plasmids laden with the data are transferred to Novablue through a process known as conjugation.
Once delivered, HB101 then travels back to a device capable of extracting the plasmids to read the data, creating a microscopic data storage system.
DNA written in seconds
In the team’s paper published online, the key to this movement was explained as being down to the use of two different antibiotics: tetracycline (Novablue-resistant) and streptomycin (HB101-resistant).
If HB101 wants to travel, it needs to pick up its resistance to tetracycline by conjugating with Novablue, which allows HB101 to gather the data.
Speaking of its potential, WIT’s Dr Lee Coffey said that a number of challenges remain before it can be used effectively, notably the time it takes to transfer.
“Potentially, DNA can be written down to seconds; there are instruments around a long time that can do this,” he said.
“In terms of transfer of DNA between different bacteria and cells, that’s happening with millions of billions of cells at one time per second in a reaction. So, if we are talking about data transfer – getting cells to take DNA for us from A to B – at the moment, it is a matter of how fast can they swim.”
There are also the issues of data security and bringing the cost down before data can be secured in the real world.
Colm Gorey
This article originally appeared on www.siliconrepublic.com and can be found at:
https://www.siliconrepublic.com/innovation/dna-ecoli-data-storage